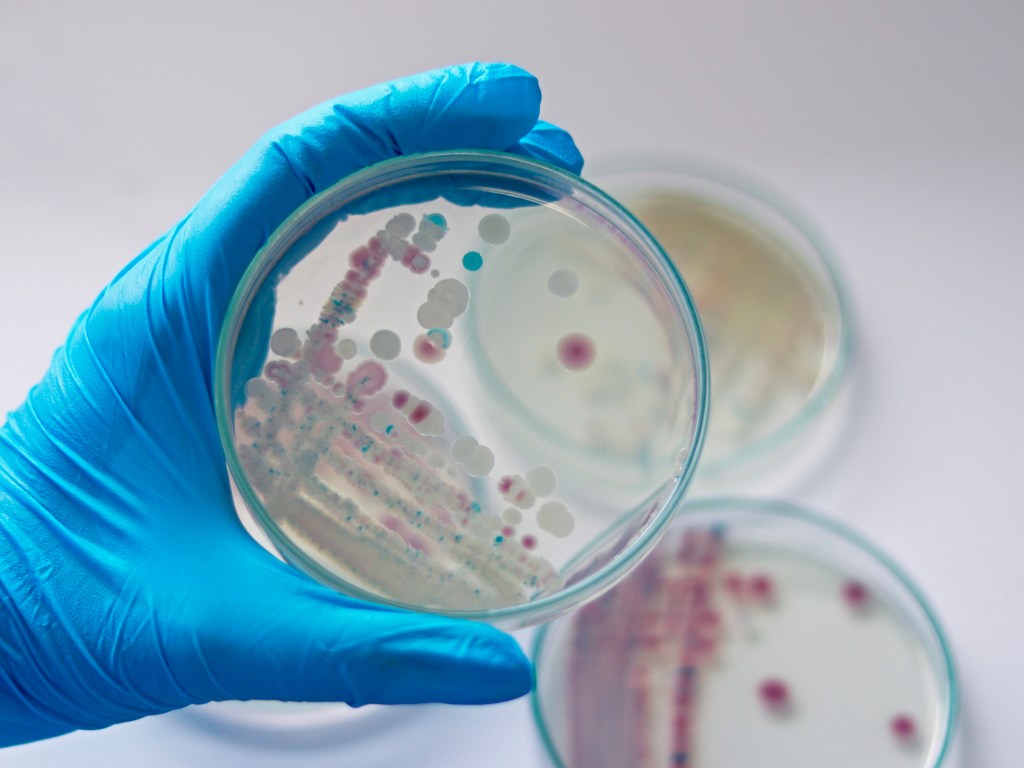

Los Centros de Control y Prevención de Enfermedades de Estados Unidos alertó sobe la bacteria carnívora Vibrio vulnificus, pues representa una amenaza seria para la salud.
Los expertos informaron que la bacteria se encuentra en las aguas costeras, causa infecciones potencialmente mortales, principalmente en personas con sistemas inmunitarios debilitados o enfermedades del hígado.
En Estados Unidos la bacteria fue considerada rara, pero con consecuencias devastadoras para quienes la contraen.
Esta bacteria habita de forma natural en las aguas costeras, y generalmente se convierte en una amenaza cuando entra en contacto con heridas abiertas, ya sea a través de la contaminación de una herida preexistente o cuando alguien resulta herido mientras está expuesto a agua salobre o salada.
Los síntomas de una infección por Vibrio vulnificus pueden variar según la vía de infección, pero algunos son diarrea acuosa, calambres estomacales, náuseas, vómitos y fiebre.